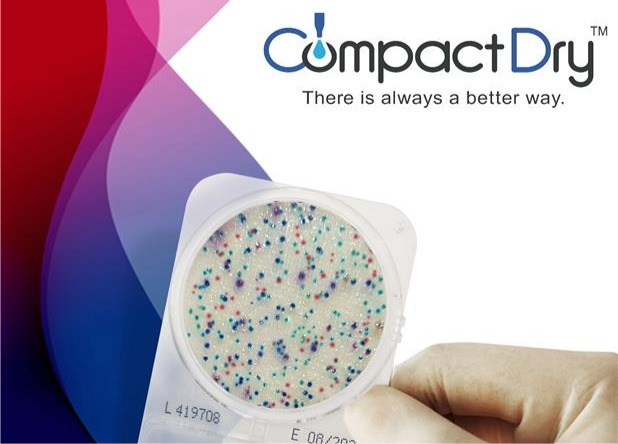
Compact Dry

Featured Articles
News / Event
-
Singapore International Water Week (SIWW) 2026
We are glad to have participated in the Singapore International Water Week (SIWW) 2026 from 16 to 18 June. We have showcased our all new online TOC analyzer to do continuous analysis of TOC content in water treatment.
Additionally, we have launched our rapid CompactDry microbial detection plates for food, environmental and water monitoring. -
Supercritical Fluid Extraction Workshop
We had the pleasure of hosting a Supercritical Fluid Extraction workshop in collaboration with our partner, James Tunstall of Core Separations, last Thursday at the Shimadzu (Asia Pacific) office. This event marked the introduction of the SFX-100BT benchtop model to our customers in Singapore.
A special thank you to Dr. Sreenivasa Reddy Puniredd for sharing his expertise in supercritical fluid extraction, particularly in the context of research in food upcycling and valorization.
For those interested in a demonstration, please reach out to us at sgp@shimadzu.com.sg for more information. -
UV/VIS Plus Trade Up
Trade up to UV/Vis Plus spectrophotometers from Shimadzu or any other vendors!
Unlock enhanced precision, powerful Hazen Quantitation feature, and proprietary Analytical
Intelligence capabilities that boost your daily productivity with reliable data.
Upgrade NOW and save 30% with our exclusive discount!
For more information about the promotion, click here
For enquiries, contact us at sgp@shimadzu.com.sg and quote 2025SGP0901-UVi -
Shimadzu 150 Years Anniversary Customer Appreciation Event
The Shimadzu 150 years' anniversary celebration tour comes to Singapore. On 21st August, we shared this momentus occasion with our customers. We would never have gone this far without the support and partnership with our customers. Special thanks to Ms May Ong, PPA(P), PPA(P)COVID of HTX (Home Team Science & Technology Agency) as well as Dr Ichiro Hirao of Xenolis Pte Ltd for sharing the achievements resulting from the collaborations with Shimadzu (Asia Pacific).
Where we could not make it alone, collaboration is a key to success. It is double celebration for us as we witnessed the MoU signing with AuctuCel to develop cell culture optimization workflow.
Looking forward to many more years of sustainability, innovation and creativity with our customers!